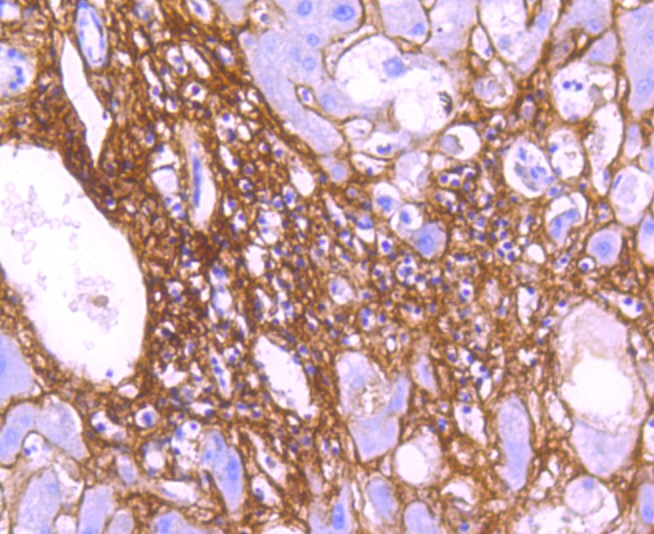

Lane 1: Mouse heart; Lane 2: Human heart; Lane 3: Human kidney; Probed with Collagen VI (9C1) Monoclonal Antibody (bsm-52703R) at 1:1000 overnight at 4°C followed by a conjugated secondary antibody for 60 minutes at 37°C.
Collagen VI (9C1) Monoclonal Antibody
BSM-52703R
ApplicationsImmunoFluorescence, Western Blot, ImmunoCytoChemistry, ImmunoHistoChemistry, ImmunoHistoChemistry Paraffin
Product group Antibodies
ReactivityHuman, Mouse, Rat
TargetCOL6A1
Overview
- SupplierBioss Antibodies
- Product NameCollagen VI (9C1) Monoclonal Antibody
- Delivery Days Customer16
- ApplicationsImmunoFluorescence, Western Blot, ImmunoCytoChemistry, ImmunoHistoChemistry, ImmunoHistoChemistry Paraffin
- Applications SupplierWB(1:300-5000), IHC-P(1:200-400), IF(ICC)(1:50-200), IHC()
- CertificationResearch Use Only
- ClonalityMonoclonal
- Clone ID9C1
- Concentration1 ug/ul
- ConjugateUnconjugated
- Gene ID1291
- Target nameCOL6A1
- Target descriptioncollagen type VI alpha 1 chain
- Target synonymsalpha 1 (VI) chain (61 AA); BTHLM1; collagen alpha-1(VI) chain; collagen VI, alpha-1 polypeptide; collagen, type VI, alpha 1; epididymis secretory sperm binding protein; OPLL; UCHMD1
- HostRabbit
- IsotypeIgG
- Protein IDP12109
- Protein NameCollagen alpha-1(VI) chain
- ReactivityHuman, Mouse, Rat
- Storage Instruction-20°C
- UNSPSC12352203